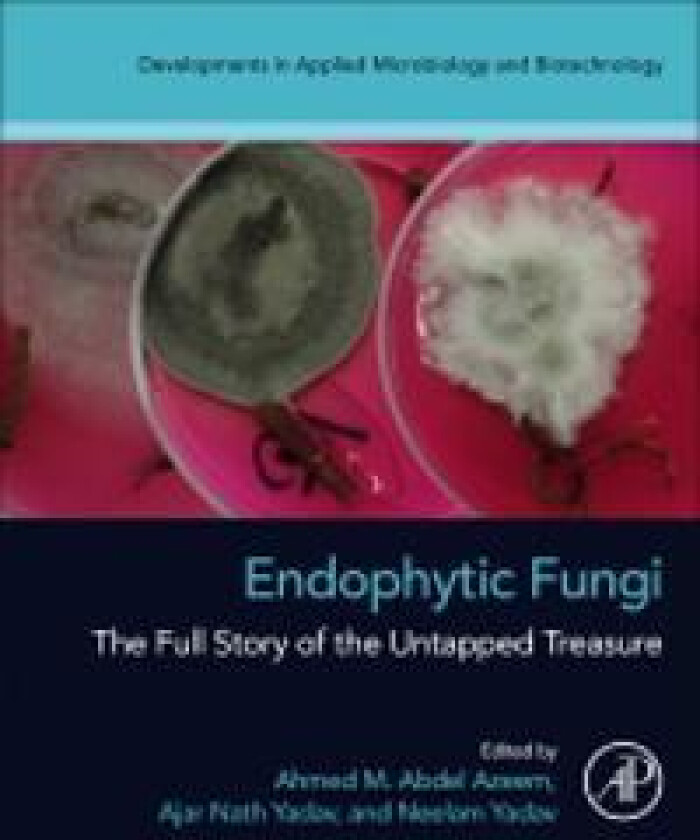

ELSEVIER SCIENCE & TECHNOLOGYEndophytic Fungi
Beste pris fra kr 1 666 og finnes i 1 butikk.
Populære alternativer
Populære merker innen Bøker
Endophytic Fungi
På lager
Prishistorikk
Prisvarsel
Meld deg opp til prisvarsel og få beskjed med en gang prisen synker.
kr
Strekkoder
GTIN
9780323993142








